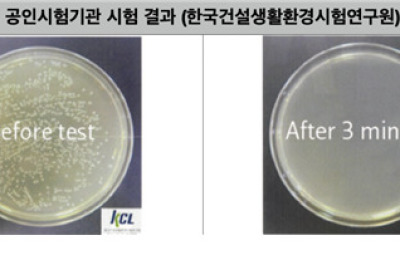

" 히포 제품" 뉴스 검색결과[총 4건] 뉴스 더 보기

" 히포 제품" 포토 검색결과[총 0건]
" 히포 제품" 에 대한 포토 검색결과가 없습니다.
" 히포 제품" 영상 검색결과[총 0건]
" 히포 제품" 에 대한 영상 검색결과가 없습니다.